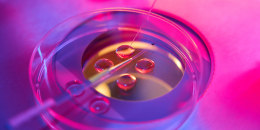

Strong bones are critical to warding off conditions like osteoporosis. While everyone’s bone mass tends to lessen as they age, low bone mass, a precursor for osteoporosis, is most common in women, per the Centers for Disease Control and Prevention. In fact, among adults older than 50 years old, 51.5% of women suffer from low bone mass compared to 33.5 % of men.
And from 2007 to 2018, prevalence in osteoporosis has increased, but only in women.
To help women better protect their bones, NBC medical contributor and rheumatologist Dr. Natalie Azar sat down with TODAY’s Hoda Kotb during a May 31 segment and shared the five habits she avoids that put her bones at risk.
I would never wait until a fracture to start thinking about osteoporosis
“About 10 million people in this country over the age of 50 have osteoporosis,” says Azar. “And we will have about 1.5 million fractures occurring in those people.” Of those who get fractures, 80% are female.
While screening for bone density typically happens at age 65, certain medications, illnesses and family history contribute to your bone health and might make you a candidate for earlier screening, says Azar, so talk to your doctor.
I would never ignore calcium intake in childhood and adolescence
Girls, says Azar, typically achieve 90% of their peak bone mass at 18 and boys at 20. “In your mid-30s, you’re already starting to lose your bone mass,” says Azar.
So, ensure the children in your life are getting enough calcium, especially during puberty, when bone growth is most rapid. According to the Food and Drug Administration, most children aren’t consuming enough calcium, so keep an eye out for foods that have 20% or more of the daily value of calcium per serving.
The recommended daily value for calcium, per the FDA, is 700 milligrams for children between 1 and 3. That goes up to 1,300 milligrams for children older than 4 and for adults.
While milk was long touted as the superior source of calcium, if you’re not a fan, not to worry. There are other ways for children (and adults alike) to up their calcium intake.
I would never get all my calcium from supplements
Instead, Azar says to turn to calcium-rich foods. While supplements can certainly provide calcium, she prefers her patients eat whole foods instead. And if dairy isn’t your thing, there are plenty of other ways to make sure you’re providing your bones with enough calcium including, “soy milk, salmon, kale, chia (and) hard tofu,” she says, adding that there are “tons of sources of nondairy calcium.”
I would never smoke or drink in excess
“Smoking and alcohol can both be detrimental to your health,” says Azar. When it comes to drinking, she says you don’t have to cut out alcohol completely, but in order to protect your bones, she recommends her patients steer clear of excessive drinking, which she describes as three or more drinks per day.
I would never slow down or stop exercising
Exercise is key for “strength and balance and coordination and flexibility,” says Azar. Wrist and hip fractures, she adds, are typically the result of falls, and exercise can help stave those off.
“We want to make sure that we’re maintaining our strength and our flexibility as we get older,” Azar says.
You might also consider fall-proofing your home with non-skid pads, adequate lighting and handrails. Furnishing your home with these things “can prevent a lot of osteoporotic fractures in this country,” Azar adds.